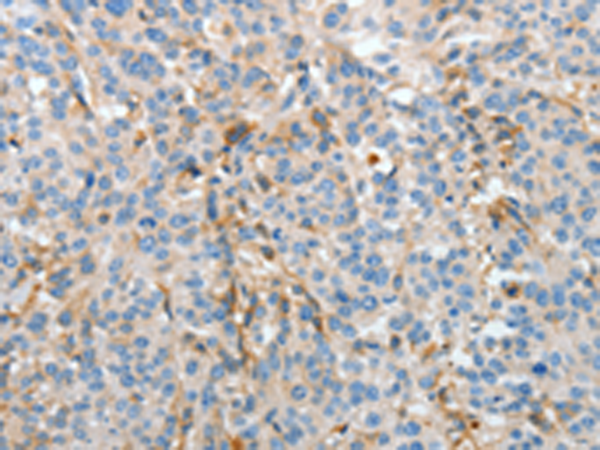

-
分类: 科研抗体货号: P07128别名: GAF; FGF-9; SYNS3; HBFG-9; HBGF-9应用: WB,IHC反应种属: Human, Mouse, Rat
-
分类: 科研抗体货号: P07106别名: BBS3, RP55应用: IHC反应种属: Human, Mouse
-
分类: 科研抗体货号: P07118别名: APPL; DIP13alpha应用: WB,IHC反应种属: Human, Mouse
-
分类: 科研抗体货号: P07127别名: DTL; BAFF; BLYS; CD257; TALL1; THANK; ZTNF4; TALL-1; TNFSF20应用: IHC反应种属: Human
-
分类: 科研抗体货号: P07101别名: HSN; SNL; p55; FAN1应用: WB反应种属: Human, Mouse, Rat
-
分类: 科研抗体货号: P07117别名: BG; B2G1; B2GP1应用: WB,IHC反应种属: Human
-
分类: 科研抗体货号: P07125别名: ATP6B应用: WB,IHC反应种属: Human, Mouse, Rat
-
分类: 科研抗体货号: P07100别名: PAS3; MUC-15; PASIII应用: IHC反应种属: Human
-
分类: 科研抗体货号: P07115别名:应用: WB反应种属: Bovine
-
分类: 科研抗体货号: P07135别名: IRIS; PSCP; BRCAI; BRCC1; PNCA4; RNF53; BROVCA1; PPP1R53应用: IHC反应种属: Human

鄂公网安备42018502007531号
鄂公网安备42018502007531号

